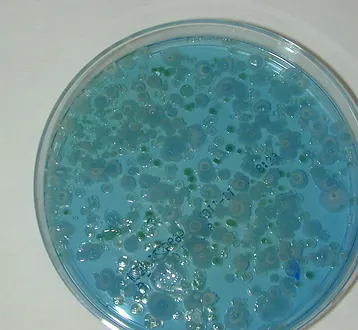

El OZONO
¿Por qué el OZONO?
Según la OMS, el ozono es el desinfectante más eficiente para todo tipo de microorganismos.
La primera vez que se utilizó con este propósito tuvo lugar en 1893 en una planta de purificación de agua en Holanda, hoy existen en este país más de 3000 plantas de depuración de aguas con ozono. Desde entonces ha ido ganando en popularidad y es empleado cada vez más por industrias y particulares para la desinfección. Una de las industrias donde es especialmente útil es la industria del vino.
Las principales ventajas que aporta el ozono son:
- Elimina los olores y sabores.
- No deja residuos.
- Es compatible con otros tratamientos.
- No afecta el pH.
- No colorea.
- Elimina la mayoría de los patógenos.

La eliminación de microorganismos indeseables mediante ozono, reduce las pérdidas ocasionadas por la alteración del vino.
Desinfecta eficazmente las barricas en pocos minutos, gracias a la reducción de microorganismos de hasta un 99,6%.
Alarga la vida útil de estas, reduciendo la colmatación de las duelas, y regenerando su micro-oxigenación, consiguendo volver a aportar al vino las sustancias propias de la madera que se habian reducido por dicha colmatación.
Disminuye el consumo de aguas de lavado y enjuagues.
Sustituye a la pajuela o azufre y al lavado con productos químicos, sin dejar ningún residuo que pueda comprometer las características organolépticas del vino.
También se pueden desinfectar tinas, foudres, depósitos, líneas de embotellado, trenes de lavado, tolvas, prensas, conducciones, superficies diversas, corchos (erradicación de TCA) y utensilios de vendimia.
FAQ
¿Desea Mas información?
Ponemos a su disposición una extensa biblioteca con información, ensayos, pruebas y otros trabajos técnico-cientificos referentes al uso del OZONO en la industria del vino. Simplemente pulse el botón.